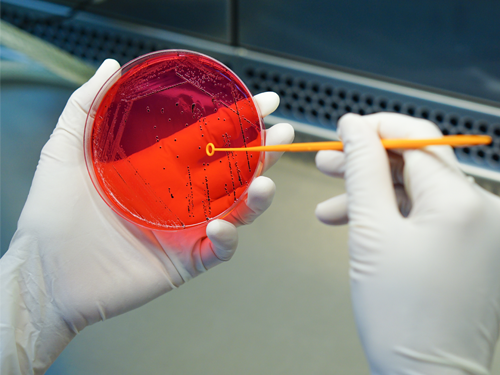

Why Cheap Disposable Gloves Aren't a Bargain
Discover why opting for cheap disposable gloves can lead to hidden costs and risks, and learn the benefits of prioritising quality and ethical sourcing.

The auto industry is the biggest user of butadiene (synthetic rubber), used specifically in the manufacture of car tires. With car sales in China almost doubling in the last year, the subsequent sharp increase in butadiene price has been passed onto glove manufacturers, who in turn are passing these rising costs to suppliers and consumers.